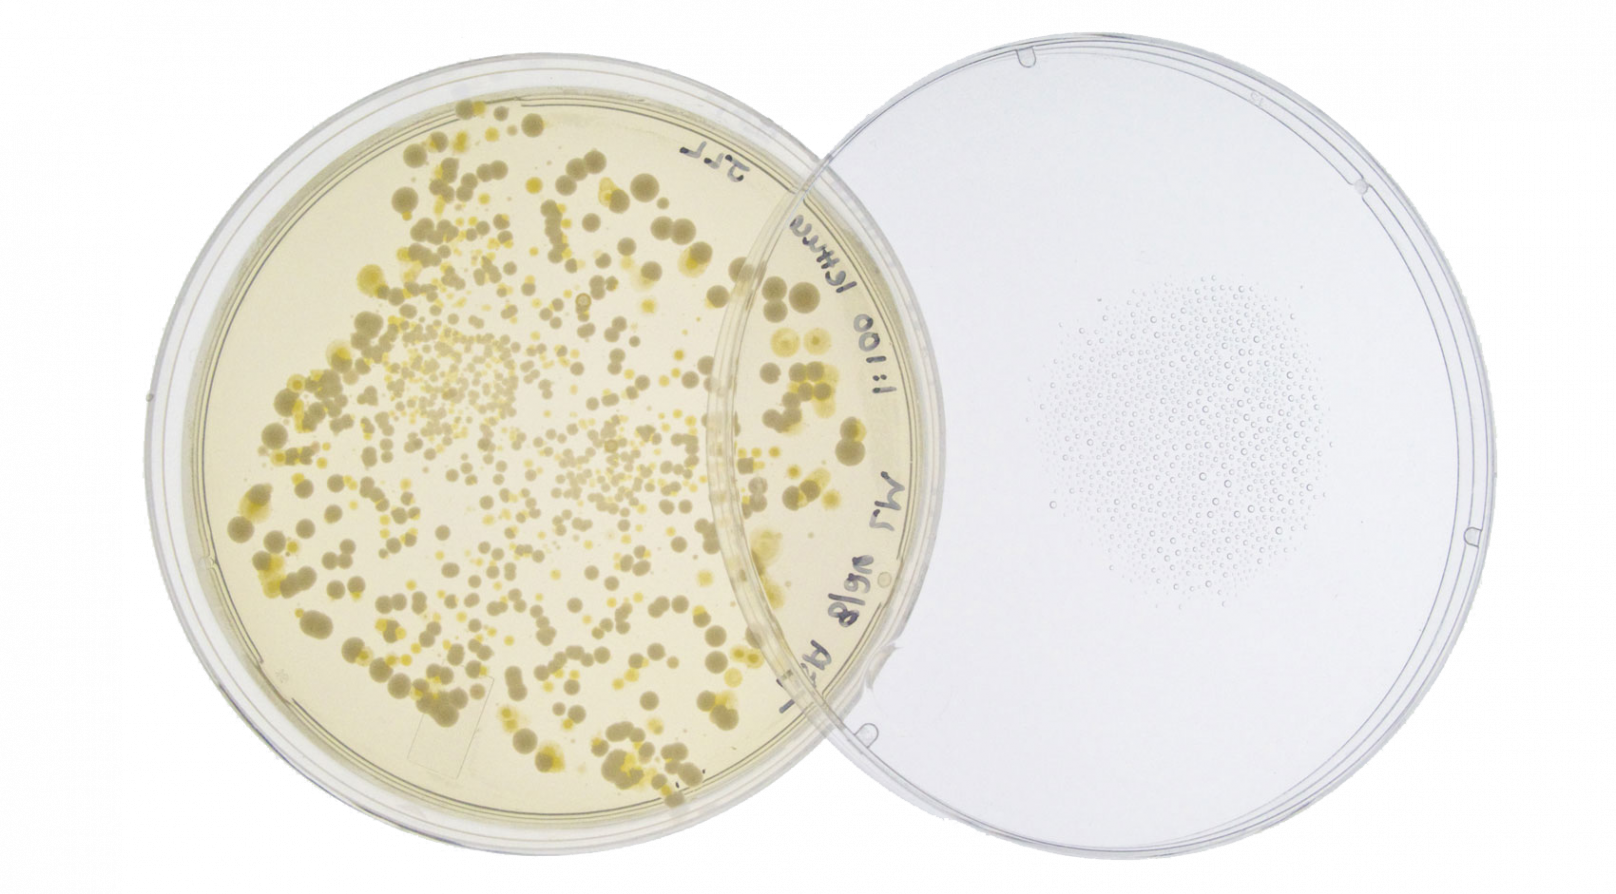
Hygi&euml;ne - vroeger, nu en in de toekomst_445

Lees verder
In dit magazine staat het thema ‘hygiëne’ centraal. Maar wat bedoelen we nou precies met de term hygiëne? Vraag het op straat en je zult veel verschillende antwoorden krijgen. De één associeert het met ‘schoon en fris’, een ander denkt puur aan persoonlijke hygiëne en weer een ander ziet het als een ‘4 log reductie van microben’. Het zal je niet verbazen dat bij deze verschillende gedachtegangen ook een groot verschil hoort in hoe het belang van hygiëne wordt ingeschat. Deze verschillen zorgen voor grote uitdagingen in het communiceren over het onderwerp. In dit artikel wordt dan ook uitgebreid aandacht besteedt aan de term hygiëne: sinds wanneer praten we erover, hoe moet er vandaag de dag naar gekeken worden, en wat wordt het belang van hygiëne in de toekomst?
Deze tekst is opgesteld op basis van de presentatie van dr. John Hines (Sc Johnson Professional) op het Hygiëneforum van 2017.
Hygiëne in het verleden
We moeten ver terug in het verleden om de oorsprong van de term ‘hygiëne’ te achterhalen, en wel naar de tijd van de oude Grieken. In die periode werd gesproken van ὑγιεινή (τέχνη) hugieinē technē, de ‘kunst’ van gezondheid. Er was zelfs een specifieke godin van de gezondheid en reinheid, Hygeía, die ook wel gezien word als de personificatie van de gezondheid. Hoewel er in die periode nog geen concrete link gelegd werd met het verspreiden van ziekten via microben, was men al wel bewust van het belang van ‘schoon’ voor de gezondheid. Zo bevatten verschillende religieuze teksten (van Bijbel tot Koran) al verwijzingen naar het belang van reinigen.
We moeten echter een flinke stap vooruit in de tijd om te komen tot een punt waarop de principes van hygiëne zoals we die nu kennen werden vastgesteld. Tot aan de negentiende eeuw werd de verspreiding van infectieziektes namelijk nog niet geassocieerd met microben. Ziekten werden toen puur in verband gebracht met stank en slechte lucht (de ‘miasmatheorie’). Dokter John Snow (1813-1858) was een van de eersten die het principe van ziekteverwekkers (de ‘germ theory of disease’) aan het licht bracht, toen hij een uitbraak van cholera in Londen kon herleiden tot de lokale watervoorziening.
Vanaf dat moment kwamen er steeds meer aanhangers van de ‘germ theory’ en begon de wetenschappelijke ontwikkeling naar de principes van hygiëne zoals we die nu kennen. Ignaz Semmelweis (1818 – 1865) ontdekte bijvoorbeeld dat sterftecijfers in ziekenhuizen sterk konden worden teruggebracht als artsen hun handen wasten, voordat ze patiënten behandelden. Het was Louis Pasteur (1822 – 1895) die uiteindelijk het wetenschappelijke bewijs bracht dat de ‘germ theory’ bevestigde. De pasteurisatietechniek in de voedselindustrie is naar hem vernoemd.
Dankzij de ‘germ theory’ volgden er in het begin van de 20ste eeuw vele ‘hygiënische’ ontwikkelingen die sterke invloed hadden op de algemene volksgezondheid en gemiddelde levensverwachting. Bijvoorbeeld de komst van sanitaire voorzieningen, het ophalen en verwijderen van afval en het aanbrengen van betere ventilatie in huizen. De nieuwe theorie zorgde ook voor meer focus op het belang van persoonlijke hygiëne. Tegen de tijd van de eerste wereldoorlog werd goede hygiëne gezien als maatschappelijke plicht en was het hebben van een schoon huis en lichaam iets om trots op te zijn.
In 1928 kwam de eerstvolgende grote ontwikkeling op het gebied van hygiëne: de ontdekking van het eerste antibioticum penicilline door Alexander Fleming, die er in 1945 de Nobelprijs voor Geneeskunde voor ontving. Grote stappen werden ook gemaakt op het gebied van meer preventieve gezondheidszorg dankzij de ontwikkelingen op het gebied van vaccinaties en de daaraan gekoppelde bevolkingsvaccinatieprogramma’s. Tot slot bracht de ontwikkeling van de chemie belangrijke vooruitgang op het gebied van hygiëne en volksgezondheid, waarmee schoonmaakmiddelen steeds effectiever en beter beschikbaar werden. In de 20ste eeuw werden dankzij de chemie en de ontdekkingen van antimicrobiële mechanismen bovendien de eerste ‘desinfectiemiddelen’ geproduceerd. Deze ontwikkelingen zorgden voor een sterke daling in het aantal doden door infectieziekten in de twintigste eeuw (figuur).


Hygiëne nu
De 19e en het grootste gedeelte van de 20ste eeuw kunnen dus ook wel gezien worden als de ‘gouden eeuwen’ van hygiëne en volksgezondheid. Sinds het einde van de twintigste eeuw lijkt er echter sprake te zijn van een terugval als het gaat om de verspreiding van infectieziekten. Verschillende oorzaken dragen bij aan deze terugval. Een van de meest significante oorzaken is de opkomst van antibioticaresistente ziekteverwekkers vanaf het eind van de 20ste eeuw (zie ook artikel 4)
Naast de ontwikkeling van antibioticaresistentie is de weer stijgende lijn in infectieziekten ook deels te verklaren door veranderingen in gedrag en houding bij het algemene publiek. Zo heeft de inmiddels ontkrachte hygiënehypothese veroorzaakt dat veel mensen juist bewust minder hygiënisch leven, wat bewezen gevaarlijk is voor de gezondheid. Ook de stijgende angst voor chemie heeft zijn steentje bijgedragen, waardoor mensen liever geen ‘chemische’ producten meer willen gebruiken ondanks het belang van deze producten voor de hygiëne. Mede door deze chemiefobie hebben we te maken met een overvloed aan chemische regelgeving die een steeds grotere barrière opwerpt om effectieve desinfectiemiddelen op de markt te brengen.
Deze ontwikkelingen dreigen te zorgen voor een spreekwoordelijke ‘perfecte storm’. Antibioticaresistentie lijkt ons te sturen naar een wereld waar antibiotica geen effect meer hebben, zeer effectieve desinfectiemiddelen staan onder druk door (onterechte) vraagtekens over de veiligheid en een gedragsverandering bij de burger staat ook nog eens de kennis over het belang van hygiëne op een zeer laag niveau.
Hygiëne in de toekomst
De grootste uitdaging van de nabije toekomst is dan ook: hoe kunnen we infectiepreventie door een goede hygiëne naar een hoger niveau tillen, tegelijkertijd zorgen dat de middelen niet erger zijn dan de kwaal en dat ze ook niet het vertrouwen van de mens schaden? Tijdens het Hygiëneforum op 15 oktober 2019 zal uitgebreid worden ingegaan op mogelijke antwoorden op deze vraag. Een belangrijke oplossing is al uitgebreid ter sprake gekomen tijdens de vorige editie van het Forum, het principe van doelgerichte hygiëne (zie ook artikel 2). Met dit principe wordt de focus gelegd op kritieke punten om de keten van infectie te doorbreken en dat de beschikbare middelen verstandig gebruikt worden.
Innovatie op chemisch vlak zal ook nog steeds nodig zijn om voor infectiepreventie effectieve en veilige middelen te ontwikkelen, en wet- en regelgeving moet deze ontwikkelingen juist stimuleren en niet verhinderen. Tot slot is het van belang dat het grote publiek goed en met consistente berichtgeving wordt geïnformeerd over het belang van hygiëne. Wellicht dat we dan in de toekomst, net als in de negentiende eeuw, een schoon en hygiënisch huis en lichaam weer als iets zien om trots op te zijn.














